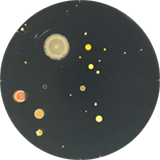
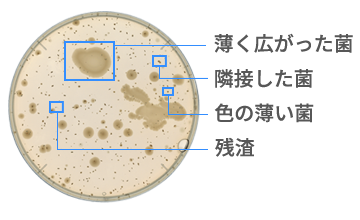

どんなサンプルも、これ一台で
菌も
-
一般生菌 
-
乳酸菌 
-
レジオネラ 
試験も
-
スパイラル 
-
環境試験
-
阻止円計測 
培地も
-
デソキシコレート 
-
酵素基質培地 
-
ペアードパーカー